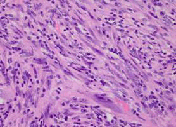

试题详情
- [材料题] 患者男,4岁,因“腹痛”来诊。剖腹探查:肠系膜上有一肿块,累及小肠。镜下形态如图所示。
- 多项选择题1.根据上述,最可能的诊断是
A、炎性肌成纤维细胞瘤
B、炎性纤维性息肉
C、胃肠间质瘤
D、滤泡树突细胞肿瘤
E、先天性纤维肉瘤
F、硬化性肠系膜炎
关注下方微信公众号,搜题查看答案

- 多项选择题2.如行免疫组织化学标记,该肿瘤可能会表达的是
A、desmin
B、CD31
C、ALK1
D、CK
E、CD117
F、CD34
关注下方微信公众号,搜题查看答案

- 多项选择题3.此肿瘤常有分子遗传学异常,表现的基因是
A、ALK
B、ATF1
C、ASPL
D、KIT
E、NF-I
F、EWS
关注下方微信公众号,搜题查看答案

热门试题
- 关于门脉高压症引起的侧支循环形成,下列哪
- 1、病理医师的设置要求是A、人员配备按每
- 肺转移性肝癌指的是A、肺癌转移到肝B、肝
- 下列平滑肌瘤中可发生于远处转移的是A、深
- 原发性输卵管癌常见的病理类型是( )
- 鼻咽癌的常见的大体类型是( )A、菜
- 基底细胞腺瘤的特征是A、不会转变为基底细
- 皮肤、黏膜和浆膜少而广泛的出血灶称为
- 血吸虫成虫所引起的病变有 ( )
- 下列选项中,与雌激素分泌增高有关的肿瘤有
- 1、最可能的诊断是2、该肿瘤的最好发部位
- 睾丸精子肉芽肿的病变特点是在睾丸实质内呈
- 55%~75%的脂肪瘤显示遗传学异常,主
- 患者,男,45岁,因高位小肠梗阻急诊入院
- 下列哪一种肿瘤与雌激素分泌无关( )
- 激发引起荧光最有效的是A、白光B、黄光C
- 关于侵袭性血管黏液瘤,叙述错误的是A、好
- 下列疾病属于器官特异性自身免疫病的是(
- 符合转移性肿瘤概念的是( )A、远隔
- 病毒性心肌炎的常见病原体主要包括(